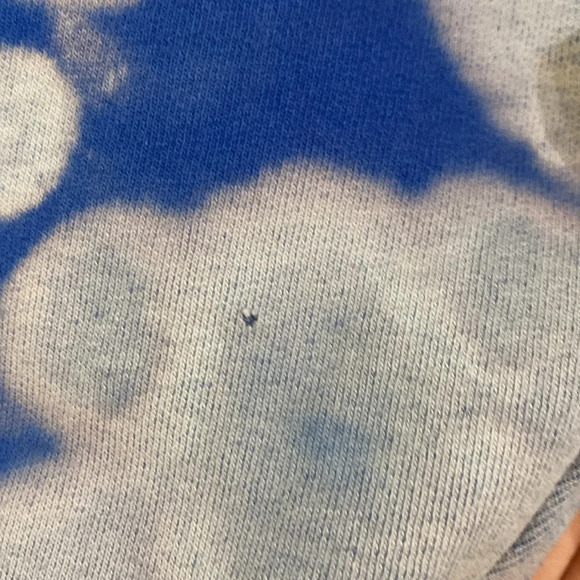
Champion Tie Dye Crew Neck Sweatshirt Medium Thrashed Grunge Holes - Picture 10 of 15

Champion Tie Dye Crew Neck Sweatshirt Medium Thrashed Grunge Holes
$5
Size
Like and save for later
Add To Bundle
Worn but still has TONS of life left. My daughter loved this sweatshirt but has grown out of it. This sweatshirt has holes and is beat up. A unique tie dye look. Champion logo on the cuff. There are holes on the cuffs under the armpit and tiny holes in different locations of the sweatshirt. Please look at photos for measurements.
#streetwear #grunge #thrashed #punk #tiedye #crewneck
Brand- Champion
Size- Medium
Color- Blue/Multi
Style- Sweatshirt
APPROX. MEASUREMENTS:
Sleeve length: 22in
Pit-Pit- 22in
Shoulder to bottom hem: 25in
*OFFERS WELCOME
**Bundle and SAVE on more items and shipping.
Fast shipping! Next day (except Sundays)!
Please message me if you have any questions.
Item# H(0)8254
Shipping/Discount





iamkimweaver
and
6 others
like this
Trending Now
Find Similar Listings
Account is under Review
Comment posting is temporarily restricted. Our team will reach out to you shortly. To understand why, select
Learn More.